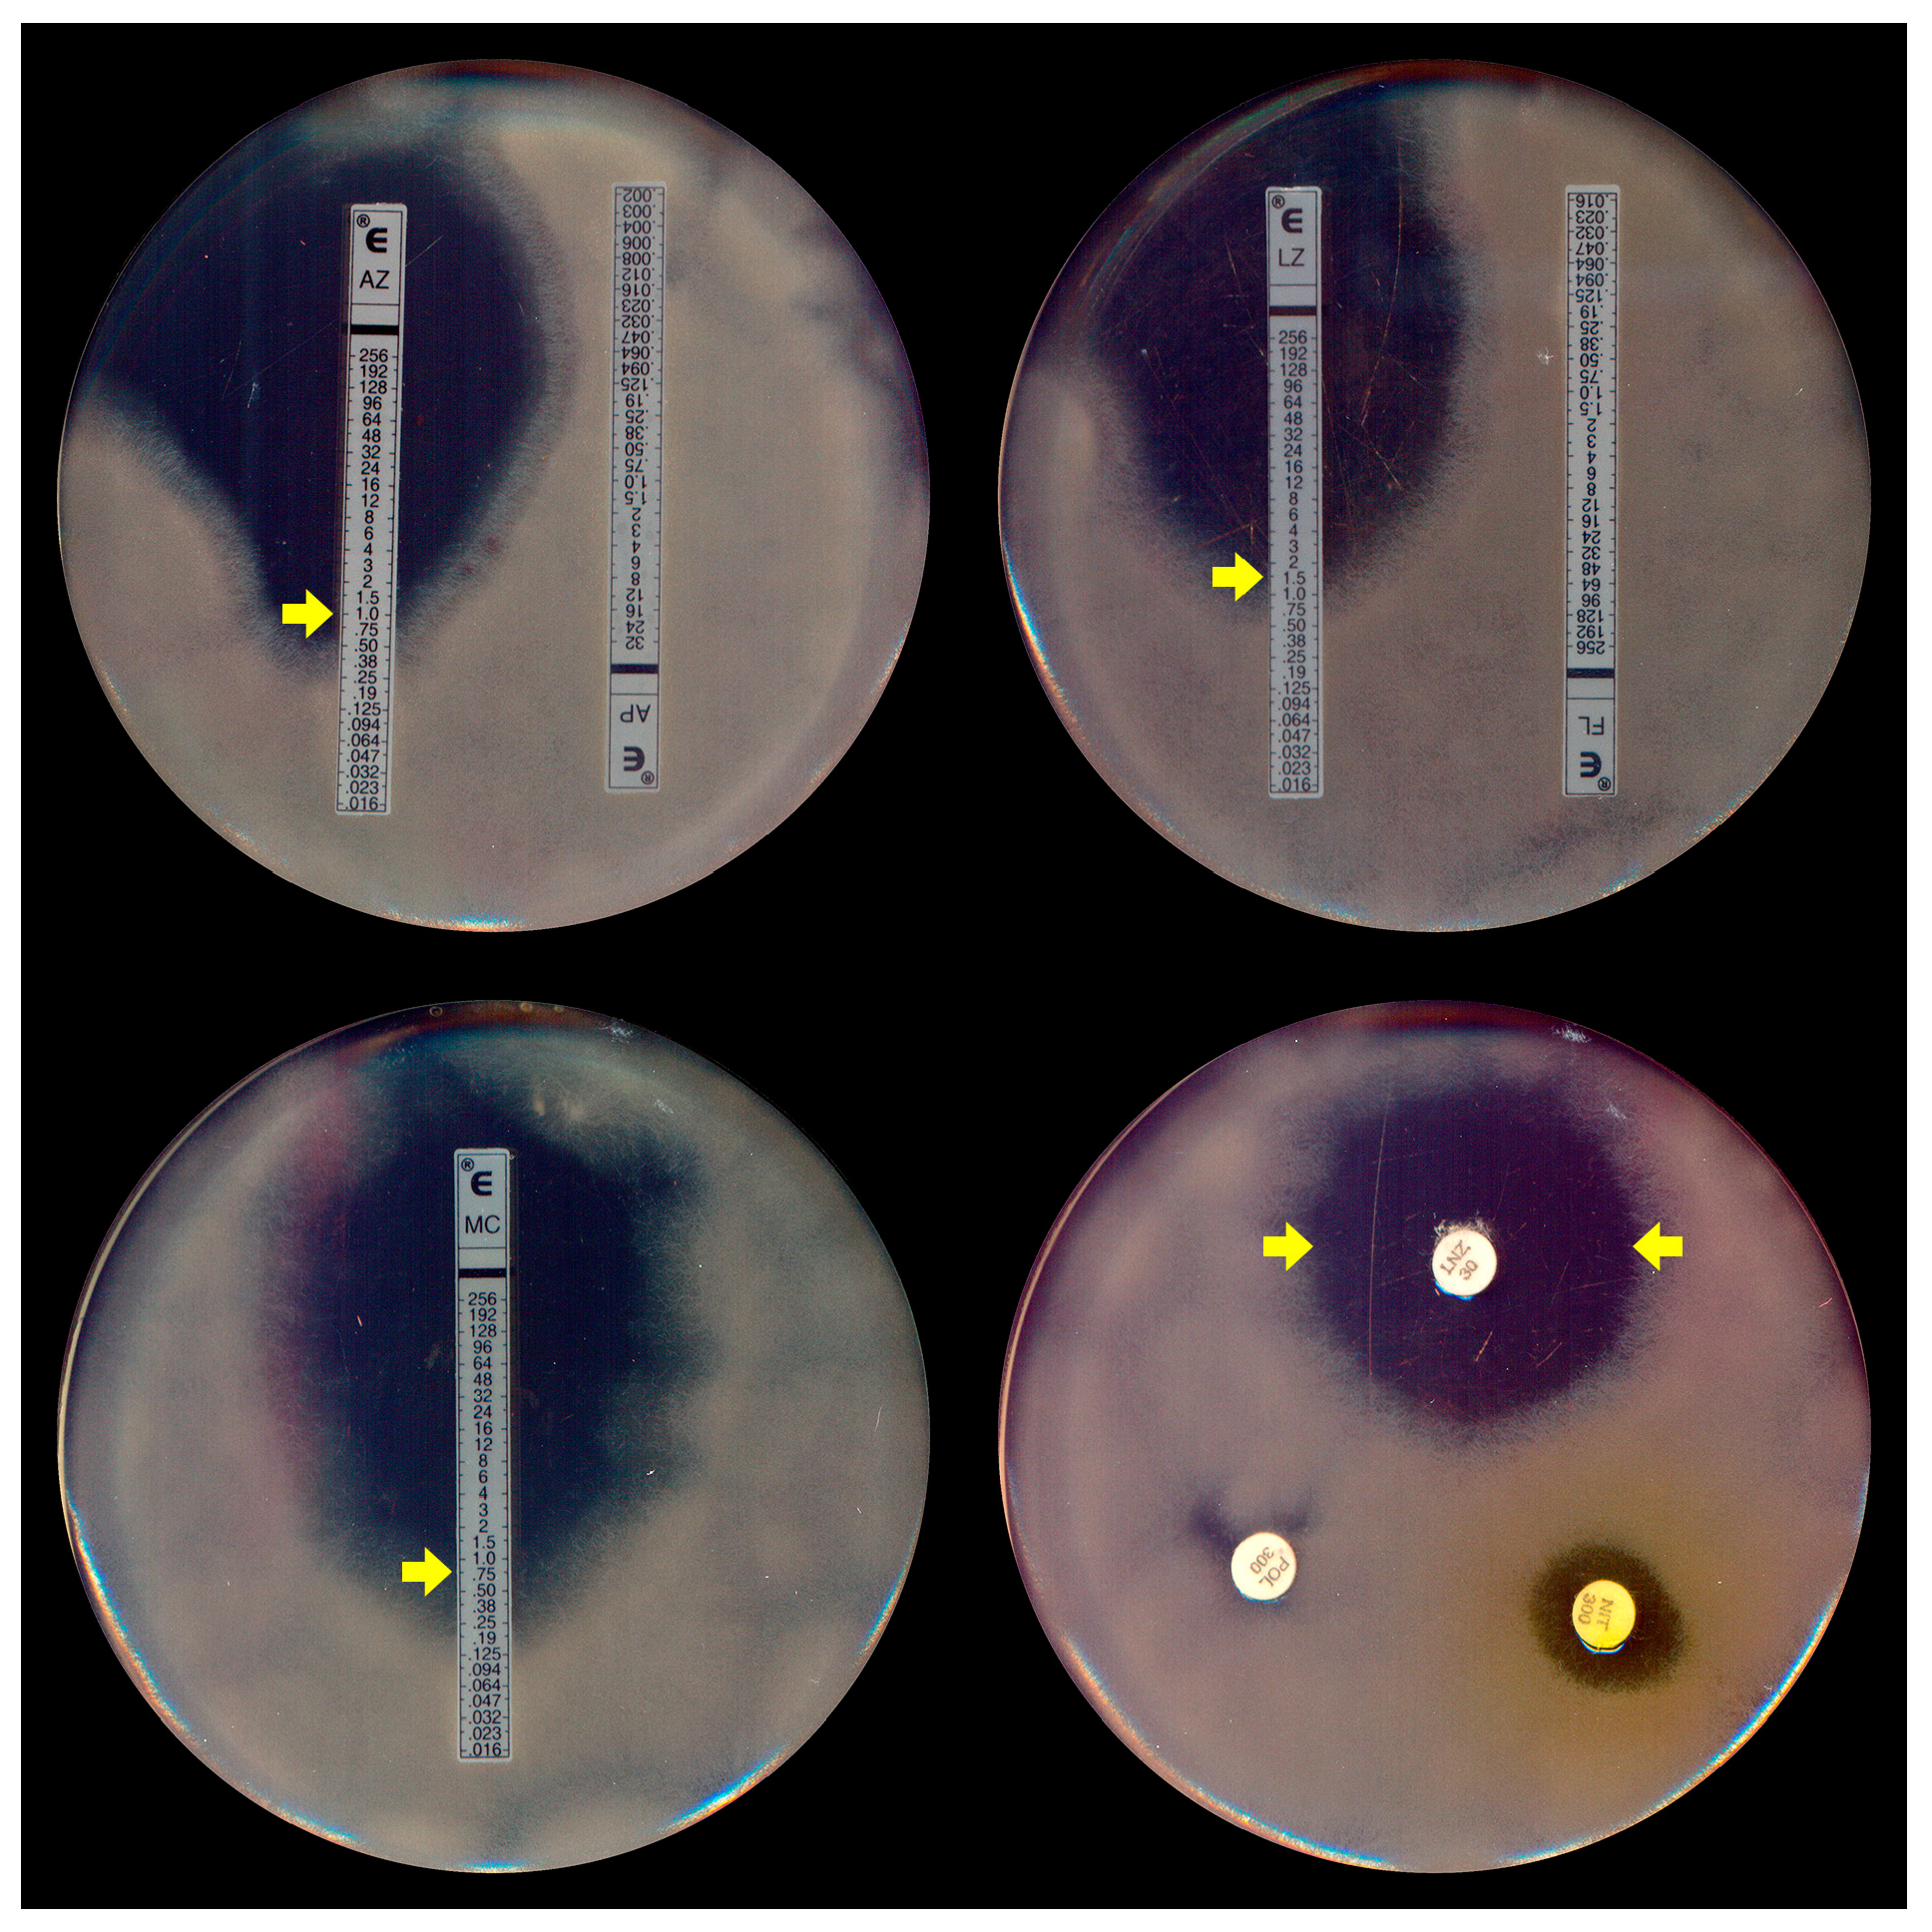
Jof 10 00234 g004

Treating Pythiosis with Antibacterial Drugs Targeting Protein Synthesis: An Overview
Abstract
1. Introduction
2. Overview of Pythiosis Treatment
3. P. insidiosum Cell Structure and Susceptibility to Antibacterial Drugs
4. In Vitro Anti-Pythium Antimicrobial Activity of Protein Synthesis-Inhibiting Antibacterials
4.1. Anti-Pythium Antimicrobial Activity Determined by Reduction in Mycelial Weight
4.2. Anti-Pythium Antimicrobial Activity Determined by Linear or Radial Growth Inhibition
4.3. Anti-Pythium Antimicrobial Activity Determined by Broth Microdilution and Gradient Strip Susceptibility Tests
5. Evaluating Protein Synthesis-Inhibiting Antibacterials in Experimental Models of Pythiosis
6. Exploring the Use of Protein Synthesis-Inhibiting Antibacterials in the Clinical Treatment of Pythiosis
7. Antibacterial Drugs and Pythiosis: Challenges from In Vitro and Experimental Susceptibility to Clinical Insights
8. Conclusions
9. Future Directions
Author Contributions
Funding
Institutional Review Board Statement
Informed Consent Statement
Data Availability Statement
Conflicts of Interest
References
- Arworn, S.; Reanpang, T.; Apichartpiyakul, P.; Orrapin, S.; Rerkasem, K. Retrospective review of management and overall survival rate of patients with vascular pythiosis of the lower extremity: 20 years experience. Int. J. Low Extrem. Wounds 2023, 15347346231214291. [Google Scholar] [CrossRef]
- Yolanda, H.; Krajaejun, T. Global distribution and clinical features of pythiosis in humans and animals. J. Fungi 2022, 8, 182. [Google Scholar] [CrossRef]
- Nguyen, D.; Vilela, R.; Miraglia, B.M.; Vilela, G.; Jasem-Alali, N.; Rohn, R.; Glass, R.; Hansen, R.D.; Mendoza, L. Geographic distribution of Pythium insidiosum infections in the United States. J. Am. Vet. Med. Assoc. 2021, 260, 530–534. [Google Scholar] [CrossRef] [PubMed]
- Gurnani, B.; Kaur, K.; Agarwal, S.; Lalgudi, V.G.; Shekhawat, N.S.; Venugopal, A.; Tripathy, K.; Srinivasan, B.; Iyer, G.; Gubert, J. Pythium insidiosum keratitis: Past, present, and future. Ophthalmol. Ther. 2022, 11, 1629–1653. [Google Scholar] [CrossRef] [PubMed]
- Permpalung, N.; Worasilchai, N.; Chindamporn, A. Human pythiosis: Emergence of fungal-like organism. Mycopathologia 2020, 185, 801–812. [Google Scholar] [CrossRef] [PubMed]
- Loreto, E.S.; Tondolo, J.S.M.; Santurio, J.M.; Alves, S.H. Screening of antibacterial drugs for antimicrobial activity against Pythium insidiosum. Med. Mycol. 2019, 57, 523–525. [Google Scholar] [CrossRef] [PubMed]
- Loreto, E.S.; Tondolo, J.S.; Pilotto, M.B.; Alves, S.H.; Santurio, J.M. New insights into the in vitro susceptibility of Pythium insidiosum. Antimicrob. Agents Chemother. 2014, 58, 7534–7537. [Google Scholar] [CrossRef]
- Bagga, B.; Sharma, S.; Madhuri Guda, S.J.; Nagpal, R.; Joseph, J.; Manjulatha, K.; Mohamed, A.; Garg, P. Leap forward in the treatment of Pythium insidiosum keratitis. Br. J. Ophthalmol. 2018, 102, 1629–1633. [Google Scholar] [CrossRef]
- Worasilchai, N.; Chindamporn, A.; Plongla, R.; Torvorapanit, P.; Manothummetha, K.; Chuleerarux, N.; Permpalung, N. In vitro susceptibility of Thai Pythium insidiosum isolates to antibacterial agents. Antimicrob. Agents Chemother. 2020, 64, e02099-19. [Google Scholar] [CrossRef]
- Medhasi, S.; Chindamporn, A.; Worasilchai, N. A review: Antimicrobial therapy for human pythiosis. Antibiotics 2022, 11, 450. [Google Scholar] [CrossRef]
- Chitasombat, M.N.; Jongkhajornpong, P.; Lekhanont, K.; Krajaejun, T. Recent update in diagnosis and treatment of human pythiosis. PeerJ 2020, 8, e8555. [Google Scholar] [CrossRef] [PubMed]
- Yolanda, H.; Krajaejun, T. History and perspective of immunotherapy for pythiosis. Vaccines 2021, 9, 1080. [Google Scholar] [CrossRef] [PubMed]
- Mendoza, L. Pythium insidiosum and mammalian hosts. In Oomycete Genetics and Genomics: Diversity, Interactions and Research Tools; Lamour, K., Kamoun, S., Eds.; John Wiley & Sons: Hoboken, NJ, USA, 2009; pp. 387–405. [Google Scholar]
- Sermsathanasawadi, N.; Praditsuktavorn, B.; Hongku, K.; Wongwanit, C.; Chinsakchai, K.; Ruangsetakit, C.; Hahtapornsawan, S.; Mutirangura, P. Outcomes and factors influencing prognosis in patients with vascular pythiosis. J. Vasc. Surg. 2016, 64, 411–417. [Google Scholar] [CrossRef]
- Permpalung, N.; Worasilchai, N.; Plongla, R.; Upala, S.; Sanguankeo, A.; Paitoonpong, L.; Mendoza, L.; Chindamporn, A. Treatment outcomes of surgery, antifungal therapy and immunotherapy in ocular and vascular human pythiosis: A retrospective study of 18 patients. J. Antimicrob. Chemother. 2015, 70, 1885–1892. [Google Scholar] [CrossRef]
- Krajaejun, T.; Sathapatayavongs, B.; Pracharktam, R.; Nitiyanant, P.; Leelachaikul, P.; Wanachiwanawin, W.; Chaiprasert, A.; Assanasen, P.; Saipetch, M.; Mootsikapun, P.; et al. Clinical and epidemiological analyses of human pythiosis in Thailand. Clin. Infect. Dis. 2006, 43, 569–576. [Google Scholar] [CrossRef]
- Barequet, I.S.; Lavinsky, F.; Rosner, M. Long-term follow-up after successful treatment of Pythium insidiosum keratitis in Israel. Semin. Ophthalmol. 2013, 28, 247–250. [Google Scholar] [CrossRef]
- Vishwakarma, P.; Bagga, B. Pythium insidiosum keratitis: Review of literature of 5 years’ clinical experience at a tertiary eye care center. Semin. Ophthalmol. 2023, 38, 190–200. [Google Scholar] [CrossRef]
- McMullan, W.C.; Joyce, J.R.; Hanselka, D.V.; Heitmann, J.M. Amphotericin B for the treatment of localized subcutaneous phycomycosis in the horse. J. Am. Vet. Med. Assoc. 1977, 170, 1293–1298. [Google Scholar]
- Thianprasit, M.; Chaiprasert, A.; Imwidthaya, P. Human pythiosis. Curr. Top. Med. Mycol. 1996, 7, 43–54. [Google Scholar]
- Lerksuthirat, T.; Sangcakul, A.; Lohnoo, T.; Yingyong, W.; Rujirawat, T.; Krajaejun, T. Evolution of the sterol biosynthetic pathway of Pythium insidiosum and related oomycetes contributes to antifungal drug resistance. Antimicrob. Agents Chemother. 2017, 61, e02352-16. [Google Scholar] [CrossRef] [PubMed]
- Shenep, J.L.; English, B.K.; Kaufman, L.; Pearson, T.A.; Thompson, J.W.; Kaufman, R.A.; Frisch, G.; Rinaldi, M.G. Successful medical therapy for deeply invasive facial infection due to Pythium insidiosum in a child. Clin. Infect. Dis. 1998, 27, 1388–1393. [Google Scholar] [CrossRef] [PubMed]
- Hummel, J.; Grooters, A.; Davidson, G.; Jennings, S.; Nicklas, J.; Birkenheuer, A. Successful management of gastrointestinal pythiosis in a dog using itraconazole, terbinafine, and mefenoxam. Med. Mycol. 2011, 49, 539–542. [Google Scholar] [CrossRef] [PubMed]
- Dória, R.G.S.; Carvalho, M.B.; Freitas, S.H.; Laskoski, L.M.; Colodel, E.M.; Mendonca, F.S.; Silva, M.A.; Grigoletto, R.; Fantinato Neto, P. Evaluation of intravenous regional perfusion with amphotericin B and dimethylsulfoxide to treat horses for pythiosis of a limb. BMC Vet. Res. 2015, 11, 152. [Google Scholar] [CrossRef] [PubMed]
- Loreto, É.S. Update on pythiosis immunobiology and immunotherapy. World J. Immunol. 2014, 4, 88–97. [Google Scholar] [CrossRef]
- Mendoza, L.; Newton, J.C. Immunology and immunotherapy of the infections caused by Pythium insidiosum. Med. Mycol. 2005, 43, 477–486. [Google Scholar] [CrossRef]
- Bridges, C.H.; Emmons, C.W. A phycomycosis of horses caused by Hyphomyces destruens. J. Am. Vet. Med. Assoc. 1961, 138, 579–589. [Google Scholar]
- Costa, R.O.; Macedo, P.M.; Carvalhal, A.; Bernardes-Engemann, A.R. Use of potassium iodide in dermatology: Updates on an old drug. An. Bras. Dermatol. 2013, 88, 396–402. [Google Scholar] [CrossRef]
- Sterling, J.B.; Heymann, W.R. Potassium iodide in dermatology: A 19th century drug for the 21st century-uses, pharmacology, adverse effects, and contraindications. J. Am. Acad. Dermatol. 2000, 43, 691–697. [Google Scholar] [CrossRef]
- Hutchins, D.R.; Johnston, K.G. Phycomycosis in the horse. Aust. Vet. J. 1972, 48, 269–278. [Google Scholar] [CrossRef]
- Murray, D.R.; Ladds, P.W.; Johnson, R.H.; Pott, B.W. Metastatic phycomycosis in a horse. J. Am. Vet. Med. Assoc. 1978, 172, 834–836. [Google Scholar]
- Ader, P.L. Phycomycosis in fifteen dogs and two cats. J. Am. Vet. Med. Assoc. 1979, 174, 1216–1223. [Google Scholar] [PubMed]
- Rodrigues, V.S.; Trevisan, L.A.C.; Cintra, B.S.; Pires, R.H.; Ribeiro, A.B.; Tavares, D.C.; Oberhaus, E.; Ferreira, J.C. Effectiveness of photo-ozone therapy against equine Pythium insidiosum. J. Equine Vet. Sci. 2024, 134, 105030. [Google Scholar] [CrossRef]
- Sedrish, S.A.; Moore, R.M.; ValdesVasquez, M.A.; Haynes, P.F.; Vicek, T. Adjunctive use of a neodymium:yttrium-aluminum-garnet laser for treatment of pythiosis granulomas in two horses. J. Am. Vet. Med. Assoc. 1997, 211, 464–465. [Google Scholar] [CrossRef]
- Pires, L.; Bosco Sde, M.; Baptista, M.S.; Kurachi, C. Photodynamic therapy in Pythium insidiosum—An in vitro study of the correlation of sensitizer localization and cell death. PLoS ONE 2014, 9, e85431. [Google Scholar] [CrossRef]
- Pires, L.; Bosco Sde, M.; da Silva, N.F., Jr.; Kurachi, C. Photodynamic therapy for pythiosis. Vet. Dermatol. 2013, 24, 130–136.e30. [Google Scholar] [CrossRef]
- Zanette, R.A.; Alves, S.H.; Pilotto, M.B.; Weiblen, C.; Fighera, R.A.; Wolkmer, P.; Flores, M.M.; Santurio, J.M. Iron chelation therapy as a treatment for Pythium insidiosum in an animal model. J. Antimicrob. Chemother. 2013, 68, 1144–1147. [Google Scholar] [CrossRef]
- Sriphana, U.; Thongsri, Y.; Ardwichai, P.; Poopasit, K.; Prariyachatigul, C.; Simasathiansophon, S.; Yenjai, C. New lignan esters from Alyxia schlechteri and antifungal activity against Pythium insidiosum. Fitoterapia 2013, 91, 39–43. [Google Scholar] [CrossRef]
- Fonseca, A.O.; Pereira, D.I.; Botton, S.A.; Potter, L.; Sallis, E.S.; Junior, S.F.; Filho, F.S.; Zambrano, C.G.; Maroneze, B.P.; Valente, J.S.; et al. Treatment of experimental pythiosis with essential oils of Origanum vulgare and Mentha piperita singly, in association and in combination with immunotherapy. Vet. Microbiol. 2015, 178, 265–269. [Google Scholar] [CrossRef]
- Trolezi, R.; Azanha, J.M.; Paschoal, N.R.; Chechi, J.L.; Dias Silva, M.J.; Fabris, V.E.; Vilegas, W.; Kaneno, R.; Fernandes Junior, A.; Bosco, S.M. Stryphnodendron adstringens and purified tannin on Pythium insidiosum: In vitro and in vivo studies. Ann. Clin. Microbiol. Antimicrob. 2017, 16, 7. [Google Scholar] [CrossRef]
- Sriphana, U.; Thongsri, Y.; Prariyachatigul, C.; Pakawatchai, C.; Yenjai, C. Clauraila E from the roots of Clausena harmandiana and antifungal activity against Pythium insidiosum. Arch. Pharm. Res. 2013, 36, 1078–1083. [Google Scholar] [CrossRef]
- Burki, F.; Roger, A.J.; Brown, M.W.; Simpson, A.G.B. The new tree of eukaryotes. Trends Ecol. Evol. 2020, 35, 43–55. [Google Scholar] [CrossRef]
- McCarthy, C.G.P.; Fitzpatrick, D.A. Phylogenomic reconstruction of the oomycete phylogeny derived from 37 genomes. mSphere 2017, 2, e00095-17. [Google Scholar] [CrossRef]
- Thines, M. Oomycetes. Curr. Biol. 2018, 28, R812–R813. [Google Scholar] [CrossRef]
- Aronson, J.M.; Cooper, B.A.; Fuller, M.S. Glucans of Oomycete cell walls. Science 1967, 155, 332–335. [Google Scholar] [CrossRef]
- Judelson, H.S.; Blanco, F.A. The spores of Phytophthora: Weapons of the plant destroyer. Nat. Rev. Microbiol. 2005, 3, 47–58. [Google Scholar] [CrossRef]
- Tondolo, J.S.M.; Ledur, P.C.; Loreto, E.S.; Verdi, C.M.; Bitencourt, P.E.R.; de Jesus, F.P.K.; Rocha, J.P.; Alves, S.H.; Sassaki, G.L.; Santurio, J.M. Extraction, characterization and biological activity of a (1,3)(1,6)-beta-d-glucan from the pathogenic oomycete Pythium insidiosum. Carbohydr. Polym. 2017, 157, 719–727. [Google Scholar] [CrossRef]
- Meijer, H.J.; Hua, C.; Kots, K.; Ketelaar, T.; Govers, F. Actin dynamics in Phytophthora infestans; rapidly reorganizing cables and immobile, long-lived plaques. Cell Microbiol. 2014, 16, 948–961. [Google Scholar] [CrossRef]
- Seidl, M.F.; Van den Ackerveken, G.; Govers, F.; Snel, B. A domain-centric analysis of oomycete plant pathogen genomes reveals unique protein organization. Plant Physiol. 2011, 155, 628–644. [Google Scholar] [CrossRef]
- Powell, M.J.; Lehnen, L.P., Jr.; Bortnick, R.N. Microbody-like organelles as taxonomic markers among oomycetes. Biosystems 1985, 18, 321–334. [Google Scholar] [CrossRef]
- Gaulin, E.; Bottin, A.; Dumas, B. Sterol biosynthesis in oomycete pathogens. Plant Signal. Behav. 2010, 5, 258–260. [Google Scholar] [CrossRef]
- Hendrix, J.W. Sterol induction of reproduction and stimulation of growth of Pythium and Phytophthora. Science 1964, 144, 1028–1029. [Google Scholar] [CrossRef]
- Ferrarini, E.; De Roo, V.; Geudens, N.; Martins, J.C.; Hofte, M. Altering in vivo membrane sterol composition affects the activity of the cyclic lipopeptides tolaasin and sessilin against Pythium. Biochim. Biophys. Acta (BBA)-Biomembr. 2022, 1864, 184008. [Google Scholar] [CrossRef]
- Marchant, R.; Smith, D.G. The effect of chloramphenicol on growth and mitochondrial structure of Pythium ultimum. J. Gen. Microbiol. 1968, 50, 391–397. [Google Scholar] [CrossRef]
- Rawn, C.D.; Van Etten, J.L. Mechanism of antibacterial antibiotic sensitivity in Pythium ultimum. J. Gen. Microbiol. 1978, 108, 133–139. [Google Scholar] [CrossRef]
- Guo, L.Y.; Ko, W.H. Growth rate and antibiotic sensitivities of conidium and selfed-oospore progenies of heterothallic Pythium splendens. Can. J. Bot. 1994, 72, 1709–1712. [Google Scholar] [CrossRef]
- Rawn, C.D.; Schwarz, M. Protection of Pythium species against antibacterial antibiotics by cholesterol. Phytopathology 1987, 77, 319–323. [Google Scholar] [CrossRef]
- Yolanda, H.; Krajaejun, T. Review of methods and antimicrobial agents for susceptibility testing against Pythium insidiosum. Heliyon 2020, 6, e03737. [Google Scholar] [CrossRef]
- McMeekin, D. Inhibition and stimulation of growth of Pythium by streptomycin. Mycologia 1978, 70, 880–883. [Google Scholar] [CrossRef]
- McMeekin, D.; Mendoza, L. In vitro effect of streptomycin on clinical isolates of Pythium insidiosum. Mycologia 2000, 92, 371–373. [Google Scholar] [CrossRef]
- Tondolo, J.S.; Loreto, E.S.; Denardi, L.B.; Mario, D.A.; Alves, S.H.; Santurio, J.M. A simple, rapid and inexpensive screening method for the identification of Pythium insidiosum. J. Microbiol. Methods 2013, 93, 52–54. [Google Scholar] [CrossRef]
- CLSI Document M38-A2; Reference Method for Broth Dilution Antifungal Susceptibility Testing of Filamentous Fungi; Approved Standard; 2nd ed. Clinical and Laboratory Standards Institute: Wayne, NJ, USA, 2008.
- CLSI Standard M38; Reference Method for Broth Dilution Antifungal Susceptibility Testing of Filamentous Fungi; 3rd ed. Clinical and Laboratory Standards Institute: Wayne, NJ, USA, 2017.
- Tondolo, J.S.M.; Loreto, E.S.; Ledur, P.C.; Jesus, F.P.K.; Silva, T.M.; Kommers, G.D.; Alves, S.H.; Santurio, J.M. Chemically induced disseminated pythiosis in BALB/c mice: A new experimental model for Pythium insidiosum infection. PLoS ONE 2017, 12, e0177868. [Google Scholar] [CrossRef] [PubMed]
- Loreto, E.S.; Mario, D.A.; Denardi, L.B.; Alves, S.H.; Santurio, J.M. In vitro susceptibility of Pythium insidiosum to macrolides and tetracycline antibiotics. Antimicrob. Agents Chemother. 2011, 55, 3588–3590. [Google Scholar] [CrossRef] [PubMed]
- Mahl, D.L.; de Jesus, F.P.; Loreto, E.; Zanette, R.A.; Ferreiro, L.; Pilotto, M.B.; Alves, S.H.; Santurio, J.M. In vitro susceptibility of Pythium insidiosum isolates to aminoglycoside antibiotics and tigecycline. Antimicrob. Agents Chemother. 2012, 56, 4021–4023. [Google Scholar] [CrossRef] [PubMed]
- Torvorapanit, P.; Chuleerarux, N.; Plongla, R.; Worasilchai, N.; Manothummetha, K.; Thongkam, A.; Langsiri, N.; Diewsurin, J.; Kongsakpaisan, P.; Bansong, R.; et al. Clinical outcomes of radical surgery and antimicrobial agents in vascular pythiosis: A multicenter prospective study. J. Fungi 2021, 7, 114. [Google Scholar] [CrossRef] [PubMed]
- Loreto, E.S.; Tondolo, J.S.M.; Oliveira, D.C.; Santurio, J.M.; Alves, S.H. In vitro activities of miltefosine and antibacterial agents from the macrolide, oxazolidinone, and pleuromutilin classes against Pythium insidiosum and Pythium aphanidermatum. Antimicrob. Agents Chemother. 2018, 62, e01678-17. [Google Scholar] [CrossRef] [PubMed]
- Itaqui, S.R.; Verdi, C.M.; Tondolo, J.S.; da Luz, T.S.; Alves, S.H.; Santurio, J.M.; Loreto, E.S. In vitro synergism between azithromycin or terbinafine and topical antimicrobial agents against Pythium insidiosum. Antimicrob. Agents Chemother. 2016, 60, 5023–5025. [Google Scholar] [CrossRef] [PubMed]
- Ianiski, L.B.; Stibbe, P.C.; Denardi, L.B.; Weiblen, C.; Soares, M.P.; Valente, J.S.S.; Sangioni, L.A.; Pereira, D.I.B.; Santurio, J.M.; Botton, S.A. In vitro anti-Pythium insidiosum activity of amorolfine hydrochloride and azithromycin, alone and in combination. Med. Mycol. 2021, 59, 67–73. [Google Scholar] [CrossRef] [PubMed]
- Ianiski, L.B.; Maciel, A.F.; Colla, A.C.N.; Braga, C.Q.; Sangioni, L.A.; Pal, M.; Pereira, D.I.B.; Santurio, J.M.; Botton, S.d.A. Pythium insidiosum: In vitro oomicidal evaluation of telithromycin and interactions with azithromycin and amorolfine hydrochloride. J. Med. Mycol. 2024, 34, 101460. [Google Scholar] [CrossRef]
- Jesus, F.P.; Loreto, E.S.; Ferreiro, L.; Alves, S.H.; Driemeier, D.; Souza, S.O.; Franca, R.T.; Lopes, S.T.; Pilotto, M.B.; Ludwig, A.; et al. In vitro and in vivo antimicrobial activities of minocycline in combination with azithromycin, clarithromycin, or tigecycline against Pythium insidiosum. Antimicrob. Agents Chemother. 2016, 60, 87–91. [Google Scholar] [CrossRef]
- Loreto, E.S.; Tondolo, J.S.M.; de Jesus, F.P.K.; Verdi, C.M.; Weiblen, C.; de Azevedo, M.I.; Kommers, G.D.; Santurio, J.M.; Zanette, R.A.; Alves, S.H. Efficacy of azithromycin and miltefosine in experimental systemic pythiosis in immunosuppressed mice. Antimicrob. Agents Chemother. 2019, 63, e01385-18. [Google Scholar] [CrossRef]
- Zimmermann, C.E.P.; Jesus, F.P.K.; Schlemmer, K.B.; Loreto, E.S.; Tondolo, J.S.M.; Driemeier, D.; Alves, S.H.; Ferreiro, L.; Santurio, J.M. In vivo effect of minocycline alone and in combination with immunotherapy against Pythium insidiosum. Vet. Microbiol. 2020, 243, 108616. [Google Scholar] [CrossRef]
- Ahirwar, L.K.; Kalra, P.; Sharma, S.; Mohamed, A.; Mittal, R.; Das, S.; Bagga, B. Linezolid shows high safety and efficacy in the treatment of Pythium insidiosum keratitis in a rabbit model. Exp. Eye Res. 2021, 202, 108345. [Google Scholar] [CrossRef]
- Gurnani, B.; Kaur, K. Predicting prognosis based on regional prevalence, ulcer morphology and treatment strategy in vision-threatening Pythium insidiosum keratitis. Clin. Ophthalmol. 2023, 17, 1307–1314. [Google Scholar] [CrossRef] [PubMed]
- Ramappa, M.; Nagpal, R.; Sharma, S.; Chaurasia, S. Successful medical management of presumptive Pythium insidiosum keratitis. Cornea 2017, 36, 511–514. [Google Scholar] [CrossRef] [PubMed]
- Ros Castellar, F.; Sobrino Jimenez, C.; del Hierro Zarzuelo, A.; Herrero Ambrosio, A.; Boto de Los Bueis, A. Intraocular minocycline for the treatment of ocular pythiosis. Am. J. Health Syst. Pharm. 2017, 74, 821–825. [Google Scholar] [CrossRef]
- Chatterjee, S.; Agrawal, D. Azithromycin in the management of Pythium insidiosum keratitis. Cornea 2018, 37, e8–e9. [Google Scholar] [CrossRef]
- Raghavan, A.; Bellamkonda, P.; Mendoza, L.; Rammohan, R. Pythium insidiosum and Acanthamoeba keratitis in a contact lens user. BMJ Case Rep. 2018, 11, bcr-2018-226386. [Google Scholar] [CrossRef]
- Agarwal, S.; Iyer, G.; Srinivasan, B.; Benurwar, S.; Agarwal, M.; Narayanan, N.; Lakshmipathy, M.; Radhika, N.; Rajagopal, R.; Krishnakumar, S.; et al. Clinical profile, risk factors and outcome of medical, surgical and adjunct interventions in patients with Pythium insidiosum keratitis. Br. J. Ophthalmol. 2019, 103, 296–300. [Google Scholar] [CrossRef]
- Maeno, S.; Oie, Y.; Sunada, A.; Tanibuchi, H.; Hagiwara, S.; Makimura, K.; Nishida, K. Successful medical management of Pythium insidiosum keratitis using a combination of minocycline, linezolid, and chloramphenicol. Am. J. Ophthalmol. Case Rep. 2019, 15, 100498. [Google Scholar] [CrossRef]
- Ravindran, R.; Harwani, A.A.; Natarajan, R. Pythium keratitis: Clinical course of an emerging scourge. Asian J. Ophthalmol. 2020, 17, 318–323. [Google Scholar] [CrossRef]
- Bagga, B.; Kate, A.; Mohamed, A.; Sharma, S.; Das, S.; Mitra, S. Successful strategic management of Pythium insidiosum keratitis with antibiotics. Ophthalmology 2021, 128, 169–172. [Google Scholar] [CrossRef]
- Gurnani, B.; Christy, J.; Narayana, S.; Rajkumar, P.; Kaur, K.; Gubert, J. Retrospective multifactorial analysis of Pythium keratitis and review of literature. Indian J. Ophthalmol. 2021, 69, 1095–1101. [Google Scholar] [CrossRef] [PubMed]
- Hou, H.; Wang, Y.; Tian, L.; Wang, F.; Sun, Z.; Chen, Z. Pythium insidiosum keratitis reported in China, raising the alertness to this fungus-like infection: A case series. J. Med. Case Rep. 2021, 15, 619. [Google Scholar] [CrossRef] [PubMed]
- Puangsricharern, V.; Chotikkakamthorn, P.; Tulvatana, W.; Kittipibul, T.; Chantaren, P.; Reinprayoon, U.; Kasetsuwan, N.; Satitpitakul, V.; Worasilchai, N.; Chindamporn, A. Clinical characteristics, histopathology, and treatment outcomes of Pythium keratitis: A retrospective cohort study. Clin. Ophthalmol. 2021, 15, 1691–1701. [Google Scholar] [CrossRef] [PubMed]
- Sane, S.S.; Madduri, B.; Mohan, N.; Mittal, R.; Raghava, J.V.; Fernandes, M. Improved outcome of Pythium keratitis with a combined triple drug regimen of linezolid and azithromycin. Cornea 2021, 40, 888–893. [Google Scholar] [CrossRef]
- Gurnani, B.; Narayana, S.; Christy, J.; Rajkumar, P.; Kaur, K.; Gubert, J. Successful management of pediatric Pythium insidiosum keratitis with cyanoacrylate glue, linezolid, and azithromycin: Rare case report. Eur. J. Ophthalmol. 2022, 32, NP87–NP91. [Google Scholar] [CrossRef]
- Acharya, M.; Singh, A.; Nidhi, V.; Tiwari, A.; Gandhi, A.; Chaudhari, I. Outcomes of keratoplasty in a cohort of Pythium insidiosum keratitis cases at a tertiary eye care center in India. Preprints 2023, 2023060900. [Google Scholar] [CrossRef]
- Gurnani, B.; Christy, J.; Kaur, K.; Moutappa, F.; Gubert, J. Successful management of Pythium insidiosum keratitis masquerading as dematiaceous fungal keratitis in an immunosuppressed asian male. Ocul. Immunol. Inflamm. 2023, 1–4. [Google Scholar] [CrossRef]
- Kate, A.; Thigale, U.; Ponnapati, L.P.; Chaudhary, S.; Vishwakarma, P.; Sharma, S.; Bagga, B. Outcomes of therapeutic penetrating keratoplasty in Pythium insidiosum keratitis managed with a combination of antibiotics. Indian J. Ophthalmol. 2023, 71, 1868–1874. [Google Scholar] [CrossRef]
- Susaengrat, N.; Torvorapanit, P.; Plongla, R.; Chuleerarux, N.; Manothummetha, K.; Tuangsirisup, J.; Worasilchai, N.; Chindamporn, A.; Permpalung, N. Adjunctive antibacterial agents as a salvage therapy in relapsed vascular pythiosis patients. Int. J. Infect. Dis. 2019, 88, 27–30. [Google Scholar] [CrossRef]
- Thongsuk, P.; Plongla, R.; Thammahong, A.; Tiewsurin, J.; Worasilchai, N.; Chindamporn, A.; Suankratay, C. Vascular pythiosis caused by Pythium aphanidermatum: The first case report in Asia. Eur. J. Med. Res. 2021, 26, 132. [Google Scholar] [CrossRef]
- Manothummetha, K.; Torvorapanit, P.; Susaengrat, N.; Worasilchai, N.; Chindamporn, A.; Chuleerarux, N.; Bansong, R.; Wattanasoontornsakul, W.; Oranrigsupak, P.; Diewsurin, J.; et al. 374. A multicenter open-label single-arm clinical trial of combination therapy of surgery, itraconazole, doxycycline, and azithromycin for vascular pythiosis. Open Forum Infect. Dis. 2023, 10, ofad500.444. [Google Scholar] [CrossRef]
- Luangnara, A.; Chuamanochan, M.; Chiewchanvit, S.; Pattamapaspong, N.; Salee, P.; Chaiwarith, R. Pythiosis presenting with chronic swelling and painful subcutaneous lesion at right deltoid. IDCases 2023, 33, e01873. [Google Scholar] [CrossRef]
- Gurnani, B.; Kaur, K.; Venugopal, A.; Srinivasan, B.; Bagga, B.; Iyer, G.; Christy, J.; Prajna, L.; Vanathi, M.; Garg, P.; et al. Pythium insidiosum keratitis—A review. Indian J. Ophthalmol. 2022, 70, 1107–1120. [Google Scholar] [CrossRef]
- CLSI Document M51-A; Reference Method for Antifungal Disk Diffusion Susceptibility Testing of Non-Dermatophyte Filamentous Fungi; Approved Guideline; 1st ed. Clinical and Laboratory Standards Institute: Wayne, NJ, USA, 2010.
- Santos, C.E.P.; Ubiali, D.G.; Pescador, C.A.; Zanette, R.A.; Santurio, J.M.; Marques, L.C. Epidemiological survey of equine pythiosis in the Brazilian Pantanal and nearby areas: Results of 76 cases. J. Equine Vet. Sci. 2014, 34, 270–274. [Google Scholar] [CrossRef]
- Santos, C.E.; Marques, L.C.; Zanette, R.A.; Jesus, F.P.; Santurio, J.M. Does immunotherapy protect equines from reinfection by the oomycete Pythium insidiosum? Clin. Vaccine Immunol. 2011, 18, 1397–1399. [Google Scholar] [CrossRef]
- Labro, M.T. Immunomodulatory effects of antimicrobial agents. Part I: Antibacterial and antiviral agents. Expert Rev. Anti Infect. Ther. 2012, 10, 319–340. [Google Scholar] [CrossRef]
- Ruh, C.; Banjade, R.; Mandadi, S.; Marr, C.; Sumon, Z.; Crane, J.K. Immunomodulatory effects of antimicrobial drugs. Immunol. Investig. 2017, 46, 847–863. [Google Scholar] [CrossRef] [PubMed]
- Farmer, A.R.; Murray, C.K.; Driscoll, I.R.; Wickes, B.L.; Wiederhold, N.; Sutton, D.A.; Sanders, C.; Mende, K.; Enniss, B.; Feig, J.; et al. Combat-related Pythium aphanidermatum invasive wound infection: Case report and discussion of utility of molecular diagnostics. J. Clin. Microbiol. 2015, 53, 1968–1975. [Google Scholar] [CrossRef]
- Calvano, T.P.; Blatz, P.J.; Vento, T.J.; Wickes, B.L.; Sutton, D.A.; Thompson, E.H.; White, C.E.; Renz, E.M.; Hospenthal, D.R. Pythium aphanidermatum infection following combat trauma. J. Clin. Microbiol. 2011, 49, 3710–3713. [Google Scholar] [CrossRef]
- Veldhuis Kroeze, E.J.B.; van Elk, C.E.; van de Bildt, M.W.G.; van Run, P.; Foster, G.; Abou-Chakra, N.; Hare, R.K.; Kuiken, T. Infection with Pythium flevoense in a harbour porpoise (Phocoena phocoena) as a novel cause of dermatitis in marine mammals. Vet. Res. 2023, 54, 102. [Google Scholar] [CrossRef]
- White, A.G.; Smart, K.; Hathcock, T.; Tillson, D.M.; Poudel, A.; Rynders, P.; Wang, C. Successful management of cutaneous paralagenidiosis in a dog treated with mefenoxam, minocycline, prednisone, and hyperbaric oxygen therapy. Med. Mycol. Case Rep. 2020, 29, 38–42. [Google Scholar] [CrossRef]
- Spies, C.F.J.; Grooters, A.M.; Levesque, C.A.; Rintoul, T.L.; Redhead, S.A.; Glockling, S.L.; Chen, C.Y.; de Cock, A. Molecular phylogeny and taxonomy of Lagenidium-like oomycetes pathogenic to mammals. Fungal Biol. 2016, 120, 931–947. [Google Scholar] [CrossRef]

| Treatment | Key Points | Reference |
|---|---|---|
| Surgical Removal | Primary treatment method: Pythiosis is typically treated by surgically removing all affected tissues. Effectiveness It is most effective for superficial and small lesions. It can be challenging to achieve a safe margin to prevent recurrence. In such cases, surgical success rates can drop below 50%. Applicability Surgical removal is often the last therapeutic option. Particularly relevant for humans with vascular and ocular involvement. | [11,13,14,15,16,17,18] |
| Antifungal drugs | Historical classification of P. insidiosum: Initially believed to be a fungus since the 1960s. Use of antifungal drugs: Antifungal drugs were used for treatment based on the initial classification. Limited therapeutic success: These drugs have shown limited success in treating pythiosis. Reclassification as oomycete: Reclassified as an oomycete in the 1970s. This reclassification explained the poor response to antifungals. Reason for poor response to antifungals: Attributed to the absence of ergosterol in P. insidiosum’s membrane. Varied treatment outcomes: Despite limited overall success, some cases of canine, equine, and human pythiosis have been cured with antifungal drugs. | [11,19,20,21,22,23,24] |
| Immunotherapy | Immunotherapy preparation Extracellular or intracellular proteins are obtained by rupturing P. insidiosum hyphae using a cell homogenizer, sonicator, vortex shaker, or a combination of these techniques. Antigens for pythiosis immunotherapy preparation can be either cell mass or concentrated soluble antigens. Clinical application and outcome Immunotherapy was used as an adjunctive treatment with antimicrobial drugs or surgery for human pythiosis, achieving cure results of over 80%. In animals, particularly horses, immunotherapy as a primary treatment has achieved cure rates above 70%. Effectiveness was related to the lesion duration, antigen preparation methods, and immunological aspects of host response to the immunotherapeutic antigens. Mechanism of immunotherapy Shifts the cellular response mechanism: (a) Pythiosis: immune response involving eosinophil inflammation and Type 2 T helper cell (Th2) expression; leads to interleukin release, eosinophil, and mast cell mobilization. (b) Immunotherapy: immunotherapeutic antigens promote Type 1 T helper cell (Th1) expression, IL-2, and interferon-γ production; mobilizes T cells and macrophages to destroy P. insidiosum cells. Limitations of immunotherapy Does not provide long-term protection against reinfections. Treated hosts remain susceptible to subsequent infections, especially in environments similar to the initial infection. | [12,25,26] |
| Iodides | Iodides have been suggested as a possible treatment for pythiosis since the disease was first identified. Effectiveness The effectiveness of iodides has been inconsistent. Side effects They can cause serious side effects in some treated animals. Usage in treatment and outcomes Iodides have been used alone or in combination with other therapies. The outcomes of using iodides have varied. | [27,28,29,30,31,32] |
| Other adjuvant treatments | Several options were described or suggested to complement primary therapies: Neodymium/yttrium–aluminum–garnet (Nd:YAG) laser, photodynamic therapy; iron chelation therapy; plant-derived compounds, like essential oils and tannins, photo-ozone therapy. Clinical application These therapies and compounds have been evaluated through in vitro studies, experimental models, or in animal cases of pythiosis. However, the evidence is based on single studies for most of these suggested treatments. Further clinical evidence is necessary to ascertain these compounds and therapies’ true potential and practical applicability in a clinical setting. | [33,34,35,36,37,38,39,40,41] |
| Antibiotic Class | Antimicrobial Agent | MIC Range (Geometric Mean) | Technique | Strain Source (n) | Reference |
|---|---|---|---|---|---|
| Aminoglycosides | Amikacin | >32 a, 48 h >32 a, 48 h >32 a, 48 h >32 | BMD BMD BMD BMD | Human (17) Environmental (4) Animal (9) Human (8) | [9] [9] [9] [67] |
| Gentamicin | 32–64 (55.3) a, 24 h >32 a, 48 h >32 a, 48 h 16–>32 (26.91) 16–>32 a, 48 h | BMD BMD BMD BMD BMD | Animal (24) Human (17) Environmental (4) Animal (9) Human (8) | [66] [9] [9] [9] [67] | |
| Neomycin | 32–64 (55.3) a 32–>32 (32) a, 48 h >32 a, 48 h 32–>32 (32) a, 48 h 32–>32 a, 48 h | BMD BMD BMD BMD BMD | Animal (24) Human (17) Environmental (4) Animal (9) Human (8) | [66] [9] [9] [9] [67] | |
| Paromomycin | 32–64 (49.3) a, 24 h | BMD | Animal (25) | [66] | |
| Streptomycin | 32–64 (50.7) a, 24 h 16–>32 (22.63) a, 48 h >32 a, 48 h 16–>32 (26.91) a, 48 h 16–>32 a, 48 h | BMD BMD BMD BMD BMD | Animal (24) Human (17) Environmental (4) Animal (9) Human (8) | [66] [9] [9] [9] [67] | |
| Tobramycin | >1024 a, 24 h >32 a, 48 h >32 a, 48 h >32 a, 48 h >32 | BMD BMD BMD BMD BMD | Animal (28) Human (17) Environmental (4) Animal (9) Human (8) | [7] [9] [9] [9] [67] | |
| Amphenicols | Chloramphenicol | 4–>256 (23.1) a, 24 h and 4–>256 (52.5) a, 48 h 2–>256 (25.6) a, 24 h and 8–>256 (53.8) a, 48 h 16.00–256 48 h | BMD Etest Etest | Animal (28) Animal (28) Human (38) | [7] [7] [8] |
| Florfenicol | 8–>256 (25.1) a, 24 h and 16–>256 (50.2) a, 48 h | BMD | Animal (28) | [7] | |
| Fusidanes | Fusidic acid | >256 a, 24 h | BMD and Etest | Animal (28) | [7] |
| Lincosamides | Clindamycin | 4–>256 (16) a, 24 h and 4–>256 (26.9) a, 48 h 2–256 (7.6) a, 24 h and 2–>256 (14.5) a, 48 h | BMD Etest | Animal (28) Animal (28) | [7] [7] |
| Lincomycin | >256 a, 24 h | BMD | Animal (28) | [7] | |
| Macrolides and ketolides | Azithromycin | 2–32 (4.57) a, 24 h and 0.5–2 (1.11) b, 24 h 1–8 (2.9) a, 24 h and 1–16 (3.9) a, 48 h 0.03–4 (0.7) a, 24 h and 0.03–16 (1.0) a, 48 h 0.02–32 48 h 1–32 (6.96) a, 48 h and 0.5–8 (1.78) b, 48 h 2–16 (4.68) a,48 h 1–4 (3.13) a,48 h 2–16 (4.76) a, 48 h 2–8 (2.72) a, 48 h 8–64 (18.38) a, 24 h and 1–8 (2.30) b, 24 h 2–4 a, 48 h | BMD BMD Etest Etest BMD BMD BMD BMD BMD BMD BMD | Animal (26) Animal (28) Animal (28) Human (38) Animal (30) Animal (21) Human (17) Environmental (4) Animal (9) Animal (20) Human (8) | [65] [7] [7] [8] [68] [69] [9] [9] [9] [70] [67] |
| 2–32 (7.46) a, 48 h | BMD | Animal (20) | [71] | ||
| Clarithromycin | 0.5–8 (1.53) a, 24 h and 0.125–1 (0.49) b, 24 h 0.25–8 (1.8) a, 24 h and 0.25–8 (3.1) a, 48 h 0.5–16 (2.4) a, 24 h and 0.5–32 (3.9) a, 48 h 0.05–4 48 h 0.5–64 (4.49) a, 48 h and 0.5–8 (1.19) b, 48 h 0.125–8 (1.33) a, 48 h 2 (2) a, 48 h 0.125–2 (1.0) a, 48 h 0.125–2 a, 48 h | BMD BMD Etest Etest BMD BMD BMD BMD BMD | Animal (26) Animal (28) Animal (28) Human (38) Animal (30) Human (17) Environmental (4) Animal (9) Human (8) | [65] [7] [7] [8] [68] [9] [9] [9] [67] | |
| Erythromycin | 2–32 (7.58) a, 24 h and 0.5–4 (1.61) b, 24 h 1–32 (7.7) a, 24 h and 2–64 (15.5) a, 48 h | BMD BMD | Animal (26) Animal (28) | [65] [7] | |
| Josamycin | 2–64 (16) a, 48 h and 0.5–16 (2.33) b, 48 h | BMD | Animal (30) | [68] | |
| Roxithromycin | 2–128 (9.7) a, 24 h and 4–128 (20.6) a, 48 h | BMD | Animal (28) | [7] | |
| Telithromycin | 0.5–4 (1.15) a, 48 h | BMD | Animal (20) | [71] | |
| Tilmicosin | 4–128 (27.6) a, 24 h and 8–128 (42.8) a, 48 h | BMD | Animal (28) | [7] | |
| Oxazolidinones | Linezolid | 1–32 (5.6) a, 24 h and 4–32 (8.8) a, 48 h 0.5–8 (1.7) a, 24 h and 0.5–8 (2.0) a, 48 h 0.75–32 48 h 1–64 (13.30) a, 48 h and 1–32 (4.11) b, 48 h 4–32 (8.33) a, 48 h 4–16 (9.51) a, 48 h 4–8 (5.44) a, 48 h 4–8 a, 48 h | BMD Etest Etest BMD BMD BMD BMD BMD | Animal (28) Animal (28) Human (38) Animal (30) Human (17) Environmental (4) Animal (9) Human (8) | [7] [7] [8] [68] [9] [9] [9] [67] |
| Sutezolid | 4–64 (7.46) a, 48 h and 1–4 (2.24) b, 48 h | BMD | Animal (30) | [68] | |
| Tedizolid | >32 48 h | MIC Test Strip | Animal (30) | [68] | |
| Pleuromutilins | Retapamulin | 0.25–32 (1.45) a, 48 h and <0.125–32 (0.15) b, 48 h | BMD | Animal (30) | [68] |
| Tiamulin | 2–64 (16.37) a, 48 h and 1–8 (3.21) b, 48 h | BMD | Animal (30) | [68] | |
| Valnemulin | 0.25–16 (2.09) a, 48 h and <0.125–4 (0.22) b, 48 h | BMD | Animal (30) | [68] | |
| Pseudomonic Acids | Mupirocin | 2–32 (3.2) a, 24 h and 2–32 (6.9) a, 48 h 0.125–2 (0.6) a, 24 h and 0.125–4 (1.0) a, 48 h 1–8 (2.49) a, 48 h 0.06–1.50 48 h | BMD Etest BMD Etest | Animal (28) Animal (28) Animal (21) Human (38) | [7] [7] [69] [8] |
| Streptogramins | Synercid | 0.5–>32 (5.8) a, 24 h and 0.5–>32 (6.9) a, 48 h | Etest | Animal (28) | [7] |
| Tetracyclines and Glycylcyclines | Doxycycline | 0.5–8 (1.75) a, 24 h and 0.125–1 (0.35) b, 24 h 1–8 (3.3) a, 24 h and 2–16 (6.4) a, 48 h 1–8 (2.3) a, 24 h and 2–16 (5.8) a, 48 h 0.13–12 48 h 1–16 (3.69) a, 48 h 4–8 (4.76) a, 48 h 1–16 (3.43) a, 48 h 1–4 a, 48 h | BMD BMD Etest Etest BMD BMD BMD BMD | Animal (26) Animal (28) Animal (28) Human (38) Human (17) Environmental (4) Animal (9) Human (8) | [65] [7] [7] [8] [9] [9] [9] [67] |
| Minocycline | 0.125–2 (0.39) a, 24 h and 0.06–0.5 (0.08) b, 24 h 0.125–4 (0.9) a, 24 h and 0.25–4 (1.6) a, 48 h 0.06–4 (0.2) a, 24 h and 0.06–4 (0.4) a, 48 h 0.02–4 48 h 1–4 (1.63) a, 48 h 2 (2) a, 48 h 0.25–4 (1.08) a, 48 h 0.25–2 a, 48 h | BMD BMD Etest Etest BMD BMD BMD BMD | Animal (26) Animal (28) Animal (28) Human (38) Human (17) Environmental (4) Animal (9) Human (8) | [65] [7] [7] [8] [9] [9] [9] [67] | |
| Oxytetracycline | 2–32 (7.38) a, 24 h and 1–2 (1.57) b, 24 h | BMD | Animal (26) | [65] | |
| Tetracycline | 2–32 (5.96) a, 24 h and 0.5–2 (1.2) b, 24 h 1–32 (7.4) a, 24 h and 4–32 (16) a, 48 h 0.19–24 48 h | BMD BMD Etest | Animal (26) Animal (28) Human (38) | [65] [7] [8] | |
| Tigecycline | 0.25–2 (0.9) a, 24 h 0.25–4 (1.3) a, 24 h and 0.5–4 (2) a, 48 h 0.03–4 (0.2) a, 24 h and 0.03–4 (0.3) a, 48 h 0.02–1.50 48 h 1–4 (1.57) a, 48 h 2 (2) a, 48 h 0.5–2 (1.08) a, 48 h 0.5–2 a, 48 h | BMD BMD Etest Etest BMD BMD BMD BMD | Animal (24) Animal (28) Animal (28) Human (38) Human (17) Environmental (4) Animal (9) Human (8) | [66] [7] [7] [8] [9] [9] [9] [67] |
| Case Details | Treatment Regimen | Outcome and Notable Points | Reference |
|---|---|---|---|
| Ocular Pythiosis | |||
| A 42-year-old woman with presumptive Pythium keratitis. | Topical linezolid, azithromycin, and atropine sulfate; oral azithromycin. | Significant improvement by the fourth day. The infection completely resolved within three weeks. | [77] |
| A 30-year-old man with ocular pythiosis. | Before surgery: ophthalmic moxifloxacin, amikacin, vancomycin, and penetrating keratoplasty. After surgery: topical voriconazole, natamycin, voriconazole, liposomal amphotericin B, chlorhexidine, caspofungin, and cyclosporine. After P. insidiosum diagnosis: oral minocycline and terbinafine. Intracameral minocycline (during the third keratoplasty) | Initially, the condition worsened and required multiple surgeries. After a 45-day hospital stay, the patient was discharged and prescribed oral minocycline, cyclosporine, and ofloxacin eye drops. Two months later, the patient was infection free following the oral minocycline treatment. | [78] |
| Study of P. insidiosum keratitis in 114 LV Prasad Eye Institute patients. | Topical natamycin, voriconazole, and oral ketoconazole or itraconazole, used until 2016, were replaced with topical linezolid, azithromycin, and oral azithromycin. | The initial standard treatment has shown varied responses. A new regimen with antibacterial drugs has resulted in a lower rate of TPK and a higher proportion of healed ulcers. The response has been favorable within 5 to 6 days, although a complete cure may take 30 to 45 days. | [8] |
| A 7-year-old boy with P. insidiosum keratitis. | Initial treatment: topical natamycin, atropine, voriconazole, and oral analgesics. Second treatment: topical azithromycin, voriconazole, oral azithromycin, cyanoacrylate adhesive, and a bandage contact lens. | There was no improvement with the initial treatment. Improvement was noted after changing the treatment to azithromycin and voriconazole. Oral azithromycin was discontinued after four weeks, and vision improved to perception of hand movement after 13 weeks. | [79] |
| A case of keratitis, coinfected with P. insidiosum and Acanthamoeba. | Initial treatment: natamycin and moxifloxacin. After diagnosis: topical therapy supplemented with polyhexamethylene biguanide (PHMB), topical and oral linezolid, intrastromal voriconazole, topical and oral azithromycin, TPK, topical and oral prednisolone, topical fluorometholone. | The treatment was deemed successful four months postoperatively, evidenced by the clear graft. | [80] |
| Study on 46 patients with Pythium keratitis to compare various treatments. | (a) Medical management (MM) treatment, consisting of topical azithromycin and linezolid along with oral azithromycin, was applied to 1 eye upon initial presentation. (b) TPK was the primary surgical intervention for 42 eyes. (c) A surgical adjunct approach (SA), integrating TPK with cryotherapy and/or alcohol, was employed for 3 eyes. (d) Following TPK, 8 eyes received adjunct medical management (MA) with antibacterial drugs to prevent recurrence. | The most effective treatment for Pythium keratitis was TPK and, in severe cases, evisceration. Adjunctive procedures during TPK showed benefits with a lower risk of recurrence and could be considered routine care. Despite a high recurrence rate, 39 out of 46 eyes were anatomically salvaged. | [81] |
| P. insidiosum keratitis in a 20-year-old Japanese man. | Initial treatment: topical pimaricin, voriconazole, and intravenous liposomal amphotericin B. Treatment shifted to topical minocycline, chloramphenicol, and oral linezolid. | The condition worsened despite initial treatment. Significant improvement in keratitis with the new regimen. Developed corneal perforation, necessitating therapeutic penetrating keratoplasty. No recurrence of infection in the 11 months following surgery. | [82] |
| Study on two patients with P. insidiosum keratitis. | Case 1: 45-year-old male. Initial treatment: topical linezolid and azithromycin. Progression of infection led to TPK with cryotherapy and alcohol swabbing. Post-surgery: continued topical treatments and oral azithromycin. Case 2: 62-year-old male. Initial treatment: topical linezolid, azithromycin, oral azithromycin, and TPK with alcohol application and cryotherapy. Postoperative management: reduced topical antibiotics, removal of loose sutures, introduction of loteprednol and carboxymethylcellulose eye drops. | Both patients were effectively cured of P. insidiosum keratitis. Careful postoperative management was crucial for successful outcomes. | [83] |
| Retrospective analysis of 112 patients with P. insidiosum keratitis. | Sixty-nine patients were treated with topical linezolid, azithromycin, and oral azithromycin. Excluded patients with severe corneal thinning, perforations, limbal/scleral involvement, or endophthalmitis who underwent early TPK. | In total, 55.1% (38 of 69 eyes) responded to medical therapy; 34.3% required cyanoacrylate glue for tectonic support; and 44.9% (31 of 69 eyes) underwent TPK. Post-TPK: 29% of grafts remained clear, and 70.9% experienced graft failure. No recurrence of infection was observed. | [84] |
| A study involving 30 patients with Pythium keratitis. | Before culture results: topical natamycin (7 patients), natamycin and voriconazole (15), natamycin and itraconazole (8). After culture results: topical linezolid (11), linezolid and azithromycin (19). TPK in 63.3% of patients. Post-TPK: topical linezolid and azithromycin. | A total of seven patients healed with medical treatment, nineteen healed with TPK, and four were lost to follow-up. | [85] |
| Three cases of P. insidiosum keratitis in adults from China. | Case 1: 45-year-old female. Treatments: topical/systemic fluconazole, levofloxacin, cefminox sodium, intracameral fluconazole injection, lamellar keratoplasty, post-surgery amphotericin B. Case 2: 51-year-old female. Treatments: topical levofloxacin, cefminox sodium, voriconazole, TPK, intracameral fluconazole. Case 3: 55-year-old male. Treatments: topical/systemic antibiotics (ornidazole, tobramycin, vancomycin, natamycin, fluconazole), excision of pterygium, TPK, antiamebic therapy (chlorhexidine), additional voriconazole, intracameral amphotericin B. | Case 1: enucleation of right eye due to ineffective antifungal therapy and increasing infiltrate with hypopyon. Post-enucleation adjusted treatment with linezolid and azithromycin, no recurrence observed. Case 2: enucleation on day 28 post-exposure due to progressive, unresponsive infiltrates. Case 3: enucleation due to infection spreading to adjacent sclera and progressing to endophthalmitis. Despite treatments, all cases resulted in enucleation due to uncontrolled infection. | [86] |
| Retrospective review of medical records from 2006 to 2019 of patients diagnosed with Pythium keratitis. | Most were treated with at least two topical antifungal agents: natamycin and voriconazole (14 eyes, 53.8%), topical natamycin, and amphotericin B (11 eyes, 42.3%). Topical antibiotics: moxifloxacin (15 eyes), azithromycin (5 eyes), linezolid (3 eyes). Oral antifungals: terbinafine and itraconazole. TPK in 21 eyes. | Despite drug treatments, the infection progressed in 24 out of 26 cases (92.3%). After the first TPK, 6 out of 21 eyes (28.6%) showed improvement without additional surgery. However, 15 out of 21 eyes (71.4%) experienced a recurrence. Globe salvage was achieved in 11 eyes (42.3%), while enucleation was necessary in 15 eyes (57.7%). | [87] |
| A retrospective study on 21 cases of Pythium keratitis. | Topical linezolid and azithromycin, and oral linezolid. | Keratitis resolution and corneal scarring in 73.68% of cases (14 out of 19). TPK was performed in four cases due to lack of response, large infiltrates, or worsening conditions. All corneal grafts in these cases failed. Two patients underwent successful optical penetrating keratoplasty and endothelial keratoplasty. One patient with a large infiltrate and extensive intraocular infection underwent evisceration. | [88] |
| A 9-year-old boy with P. insidiosum keratitis. | Initial treatment: topical antifungals (natamycin and itraconazole), cycloplegic homatropine, and oral diclofenac. After deterioration: shift to antibacterial agents (topical linezolid and azithromycin). Intervention with cyanoacrylate glue and a bandage contact lens due to rapid progression of infiltrate and early corneal melting. | Within two weeks, signs of healing were evident; visual acuity improved to 5/60. After one month, best-corrected visual acuity (BCVA) improved to 6/12. Using cyanoacrylate glue, which has antibacterial properties, enhanced the treatment’s efficacy. | [89] |
| Retrospective study on 16 patients with P. insidiosum keratitis. | Before and after TPK: topical linezolid and azithromycin, homatropine, and oral azithromycin. After TPK: prednisolone acetate. Intracameral linezolid was used during surgery. | Nine patients (56.25%) experienced a relapse, which was managed through repeat keratoplasty, cryotherapy, or additional intracameral linezolid. Globe was salvaged in 14 out of 16 patients (87.5%). | [90] |
| A 44-year-old male patient with HIV and acute retinal necrosis developed P. insidiosum keratitis. | Initially, topical natamycin, voriconazole, cycloplegic homatropine TDS, antiglaucoma timolol, oral diclofenac with serratiopeptidase, and pantoprazole. The treatment was then shifted to topical linezolid and azithromycin, with adjuvant drugs continuing. | By the fifth week, there was an improvement, and a complete resolution was achieved after seven weeks. No recurrence was noted during the two-month follow-up. | [91] |
| Retrospective analysis of TPK in patients with P. insidiosum keratitis. | Preoperatively, topical linezolid and azithromycin. Postoperatively, topical linezolid and azithromycin, as well as oral azithromycin, are used. | Out of 238 cases, 50 cases met the inclusion criteria. The study found that patients with P. insidiosum keratitis usually require TPK despite being treated with antibacterial drugs. However, these grafts’ anatomical and functional outcomes are significantly better than antifungal regimens. Moreover, lower recurrence rates were observed in cases treated with TPK and antibacterial drugs. | [92] |
| Vascular Pythiosis | |||
| Study on two cases of intra-abdominal pythiosis treated with surgical interventions and adjunctive antibacterial therapy. | Case 1: 37-year-old male with beta-thalassemia. Initial treatment: above-knee amputation, itraconazole, and PIV immunotherapy (mixture of extracellular and intracellular proteins). Following infection persistence: oral azithromycin and itraconazole. After recurrent abdominal pain and aneurysm progression: switched to oral doxycycline and clarithromycin. Case 2: 48-year-old male with thalassemia major. Initial treatment: above-knee amputation, oral itraconazole, and immunotherapy. Following new aneurysm development and high serum BG levels: supplemented with oral azithromycin. Persistent symptoms: switched to oral voriconazole and doxycycline. Later transitioned back to itraconazole and continued with azithromycin and doxycycline. | Case 1 and 2: remained well at 64 weeks post-diagnosis. Both cases involved combined medical therapies. These cases highlight the complexity and adaptability required in managing severe pythiosis, especially in patients with underlying conditions like thalassemia. | [93] |
| A 47-year-old Thai woman with beta-thalassemia/hemoglobin E presented with acute arterial insufficiency in both legs associated with Pythium aphanidermatum infection. | The patient received treatment with itraconazole, terbinafine, azithromycin, doxycycline, and the iron chelator deferoxamine. Radical surgery was not feasible, and immunotherapy with a vaccine was unavailable. | Regrettably, the patient passed away from uncontrolled sepsis two weeks following treatment with itraconazole, terbinafine, azithromycin, doxycycline, and the iron chelator deferoxamine. | [94] |
| Multicenter, prospective cohort study on vascular pythiosis patients with underlying thalassemia. | Combination of radical surgery and antimicrobial treatment, including azithromycin, doxycycline, and antifungal agents | Four of the eight patients evaluated had residual disease postoperatively; two were managed with antimicrobials alone. One case required a second surgery; one patient succumbed five months later. | [67] |
| A clinical trial with 40 patients with vascular pythiosis. | Surgery and a combination of itraconazole, doxycycline, and azithromycin. | At the 6-month follow-up of this study, out of the total participants, 3 patients (7.5%) died due to complications including disseminated pythiosis and infections. Out of the cohort, 26 patients showed no residual disease post-operatively. In contrast, 14 patients (35%) had residual disease; among them, 1 patient (7.1%) died, while 13 patients survived. | [95] |
| Cutaneous/Subcutaneous Pythiosis | |||
| A 26-year-old pregnant woman with subcutaneous pythiosis. | Painkillers, oral doxycycline, and cloxacillin were replaced with itraconazole, azithromycin, and terbinafine. | Despite initial treatments, the condition persisted. However, after being diagnosed with pythiosis and switching treatments, the lesion regressed gradually and was successfully treated. | [96] |
Disclaimer/Publisher’s Note: The statements, opinions and data contained in all publications are solely those of the individual author(s) and contributor(s) and not of MDPI and/or the editor(s). MDPI and/or the editor(s) disclaim responsibility for any injury to people or property resulting from any ideas, methods, instructions or products referred to in the content. |
© 2024 by the authors. Licensee MDPI, Basel, Switzerland. This article is an open access article distributed under the terms and conditions of the Creative Commons Attribution (CC BY) license (https://creativecommons.org/licenses/by/4.0/).
Share and Cite
Loreto, E.S.; Tondolo, J.S.M.; Zanette, R.A. Treating Pythiosis with Antibacterial Drugs Targeting Protein Synthesis: An Overview. J. Fungi 2024, 10, 234. https://doi.org/10.3390/jof10040234
Loreto ES, Tondolo JSM, Zanette RA. Treating Pythiosis with Antibacterial Drugs Targeting Protein Synthesis: An Overview. Journal of Fungi. 2024; 10(4):234. https://doi.org/10.3390/jof10040234
Chicago/Turabian StyleLoreto, Erico S., Juliana S. M. Tondolo, and Régis A. Zanette. 2024. "Treating Pythiosis with Antibacterial Drugs Targeting Protein Synthesis: An Overview" Journal of Fungi 10, no. 4: 234. https://doi.org/10.3390/jof10040234
APA StyleLoreto, E. S., Tondolo, J. S. M., & Zanette, R. A. (2024). Treating Pythiosis with Antibacterial Drugs Targeting Protein Synthesis: An Overview. Journal of Fungi, 10(4), 234. https://doi.org/10.3390/jof10040234

